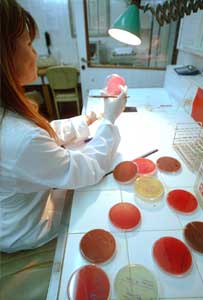

|
 |
 (1952) Los Drs. Fares Taie y Balado fundan el laboratorio en la actual dirección. (1952) Los Drs. Fares Taie y Balado fundan el laboratorio en la actual dirección.
 (1958) Los doctores Balado, Fares Taie y Mazzeo participan en la fundación del Centro Bioquímico de Mar del Plata. (1958) Los doctores Balado, Fares Taie y Mazzeo participan en la fundación del Centro Bioquímico de Mar del Plata.
 (1960/80) El Dr. Fares Taie es presidente durante 12 años de la Federación Bioquímica de la Provincia de Buenos Aires. (1960/80) El Dr. Fares Taie es presidente durante 12 años de la Federación Bioquímica de la Provincia de Buenos Aires.
 (1960) Los Drs. Balado, Fares Taie y Mazzeo ponen junto con médicos del servicio de Lactantes y prematuros del Hospital de Niños a cargo del Dr. Carlos Martín ponen en marcha los sistemas de análisis por técnicas de Micrométodos. (1960) Los Drs. Balado, Fares Taie y Mazzeo ponen junto con médicos del servicio de Lactantes y prematuros del Hospital de Niños a cargo del Dr. Carlos Martín ponen en marcha los sistemas de análisis por técnicas de Micrométodos.
 (1968) El Dr. Balado es presidente del congreso y el Dr. Fares Taie presidente de la institución que lo organiza. (1968) El Dr. Balado es presidente del congreso y el Dr. Fares Taie presidente de la institución que lo organiza.

|